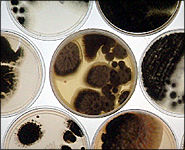

Consulting
Engineers of
Ontario

Markham
Waxers
![]()
Environmental
Abatement Council
of Ontario

Toxic
Intruder Nov. 29 - Believe it or not, families around the country are fleeing their homes — or having them destroyed — because of an insidious intruder they say is making them sick.
The invader? Black mold. Its technical name is Stachybotrys chartarum — stachy for short — and it's got a lot of people panicked. In Oregon, the O'Hara family asked their local fire department to burn their $450,000 home to the ground after black mold was found inside. "It's basically just a house that poisoned my family," Mark O'Hara said. In Hawaii, a $95 million Hilton Hotel tower has been closed since July because black mold was found in some of the rooms. In a July 2001 story Time magazine said toxic mold is spreading "like some sort of biblical plague." The New York Daily News called it "killer mold." Whatever you call it, across the country, black mold is causing people to abandon buildings, close schools and leave beautiful homes sitting vacant. In Seabrook, Texas, the Hammond family lived in tents in their backyard for almost nine months, waiting for their insurance company to settle their claim and clean up black mold they say they discovered in their home. Beverly and Mike Hammond say a bathroom leak caused the black mold to grow. The Hammonds lived for months with a "potty tent" that served as an outhouse. "As soon as I saw the mold, then we, you know, hightailed it for the tent," Beverly Hammond said. They say the mold made them sick, causing fatigue and joint pain, and will only go in their house with a respirator. Texas Dream House Turned 'Toxic Tara' Melinda Ballard's mansion near Austin, Texas is considered by many to be the "ground zero" of the current mold hysteria. Like Diane Fortner, Ballard once thought of her estate as a dream home. Ballard now refers to it as "Toxic Tara." Ballard says it all began with a leaky roof and some burst pipes. She claims her insurance company lied to her, delaying her request to have the wet materials in her home replaced. That's when she says the black mold began to grow under the kitchen floorboards and spread to other areas. Finally, she and her family left. "On April 23rd, 1999, we walked out of that home with nothing more than the clothes on our backs," Ballard said. Ballard is suing her insurance company because of the black mold. She invited 20/20 to look around her home, but insisted we wear protective suits and respirators. Ballard's case made news last year when a jury ordered her insurance company to pay her a staggering $32 million for acting in bad faith. The judgment is now being appealed. In addition to making her house unlivable, Ballard claims, the mold also caused serious health problems. She said her son, Reese, was gasping to get air into his lungs, coughing up blood and suffering terrible headaches. She said her husband, Ron, had similar symptoms, including what she calls early Alzheimer's. Ballard said, "I know men forget their anniversaries and they forget things like that, but they don't forget what kind of car they've driven. They don't forget where they live. … He did." Some scientists say memory loss and internal bleeding could be linked to mold. "You can see mucosal bleeding, like bleeding from the nose and the ears, you can see hair loss … and there are some individuals that feel that indeed cognitive dysfunction or the inability to think, is also the result of the inhalation of fungal spores," said David Straus, a microbiologist at Texas Tech. That's certainly frightening, but it's also controversial. Straus acknowledged that there is no conclusive proof that these serious illnesses are caused by black mold. However, Straus said, "The data are coming." Straus even claims his one visit to "Toxic Tara" as a consultant resulted in permanent hearing loss. "I can't prove that the hearing loss occurred because of my exposure to mold in Melinda's house," but Straus added, "that's exactly the day that it began." Turning Mold into Gold? The Centers for Disease Control and Prevention says there are very few case reports of mold in the home causing internal bleeding or memory loss, and no link has been established. Most scientists say the only proven effects from mold are allergic reactions and possible respiratory problems — including asthma. Some say mold fear is being whipped up by lawyers and mold cleanup companies eager to turn mold into gold. University of Texas Medical Center immunologist, Dr. Gailen Marshall said some of his patients have been told to leave their homes and that black mold can kill them. But Marshall insists there's no cause for alarm. "I think it's being blown horrendously out of proportion … All the stories that are out there are based primarily on testimonials and conjecture, not on hard scientific evidence," Marshall said. The stories of mold panic are so widespread — they're even being spoofed on kids' cartoon shows. The parodies of mold fear ring all too true to Gordon Stewart of the Insurance Information Institute. "There is no such thing as killer mold," Stewart said. He said mold — including black mold — has been around for centuries, and that people have only become hysterical about mold in the past few years. Two years ago, there were only 1,000 mold-related insurance claims in Texas. That number soared to 14,000 last year. And now insurers, nationwide, are raising rates or dropping mold coverage altogether. "There isn't more mold now than there was two years ago. There is more mold fear than there was two years ago, and there may be in some cases, more mold greed," Stewart said. Marshall said he does believe most of his patients complaining of mold-related illnesses really are sick. "The question is what is the relationship between the presence of mold and their illnesses? … There's really no evidence that the very presence of mold, which is really everywhere in our environment, will by itself create bleeding, will by itself create memory loss or deficit, et cetera," Marshall said. He believes what may be making some of them sick is not the mold — but the panic that's been created. Marshall insists the greatest danger isn't from the mold but from the panic that's been created. He said, "There is clear evidence that the chronic anxiety that may result from something like this itself has a negative health consequence." While there's no evidence toxic mold in the home is deadly — there is increasing debate about how dangerous it might be — and the Centers for Disease Control and Prevention is funding a study of mold's health effects. In the meantime — many families aren't taking any chances. What To Do If you see mold in your home, everyone agrees you should get rid of it. But experts say in most cases there is no need to have expensive mold remediation done. They advise homeowners to stop the water intrusion and to simply clean up the mold with a little bleach. If it has spread, experts advise homeowners to replace moldy building materials like Sheetrock. It's also important to note that not all black-colored mold is Stachybotrys chartarum. Restoration Environmental Contractors specialize in Environmental Remediation, Project Management, Demolition and Design Build General Contracting procedures and specifications for the removal of Hazardous Materials: Asbestos, Lead, Lead Paint and Lead Dust, PCB's, Mold and Fungus, UFFI, Infection Control, HEPA cleaning, Heavy Metals, Chemicals, Soils Remediation and Removal of Underground Storage Tanks, Gasoline, MTBE, Methyl Tertiary-Butyl Ether from Commercial, Residential, Institutional, Hospitals, Schools, Industrial and Manufacturing Facilities and Properties. Combined corporate staff of up to 100 professionals. |
Copyright © 1999 - 2007,
Restoration Environmental Contractors.
All rights reserved.